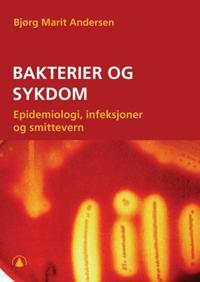
Bakterier og sykdom; epidemiologi, infeksjoner og smittevern

Pocket
Bakterier og sykdom; epidemiologi, infeksjoner og smittevern
avBjørg Marit Andersen
Beskrivning:
Denne fagboken gir en oversikt over de farligste, sykdomsfremkallende bakteriene, som bl.a. kan forekomme i helseinstitusjoner og på sykehus. Boken gir informasjon om hvordan bakteriene kan påvises og bekjempes, samt hvordan man kan sette inn forebyggende tiltak.Boken er beregnet for alle som er o [...]
Visa längre beskrivning
Fakta
- Förlag:
- Gyldendal akademisk
- ISBN:
- 9788205325517
- Bandtyp:
- Utgiven:
- 2005
- Språk:
- Norska (bokmål)
- Upplaga:
- 1 (2005)
- Antal Sidor:
- 469
- ISBN-10:
- 8205325510
Priser hos nätbutiker
| Butik | Mervärde | Pris | Tillgänglighet | Leveranstid | Inkl frakt | Länkar |
|---|---|---|---|---|---|---|
 |
Nordens största bokhandel med över 10 miljoner titlar. Alltid låga priser | 299.00 kr | I lager | 2-5 dagar | 299.00 kr | Till butik |
Obs! Glöm inte att alltid kolla priset hos återförsäljaren!

